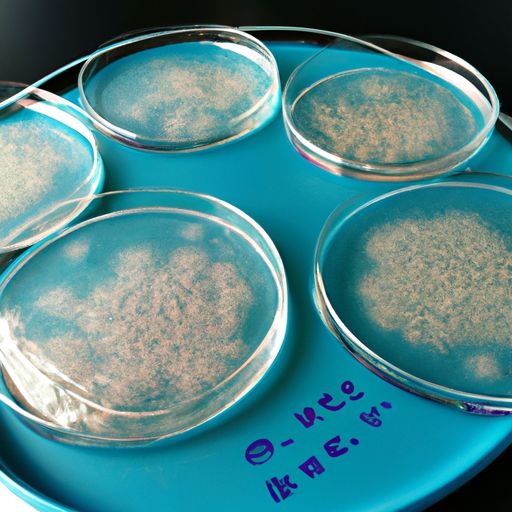
干细胞外泌体的作用 干细胞外泌体的作用

干细胞外泌体的作用
干细胞外泌体是一种非常有前途的新型治疗方法,它可以通过干细胞释放的细胞外囊泡来传递生物活性分子,从而发挥治疗作用。干细胞外泌体具有多种作用,包括促进组织修复、抗炎、抗氧化、抗凋亡、促进血管生成等。下面就分别介绍一下干细胞外泌体的这些作用。
1. 促进组织修复
干细胞外泌体中含有多种生长因子、细胞因子和胶原蛋白等,这些物质可以刺激受损组织的再生和修复。例如,干细胞外泌体可以促进心肌细胞的增殖和分化,从而促进心肌再生和修复。此外,干细胞外泌体还可以促进神经元的生长和再生,从而有望治疗神经退行性疾病。
2. 抗炎
炎症是许多疾病的共同特征,包括心血管疾病、肿瘤、糖尿病等。干细胞外泌体中含有多种抗炎因子,例如IL-10、TSG-6等,这些物质可以抑制炎症反应的发生和发展,从而有望治疗多种炎症性疾病。
3. 抗氧化
氧化应激是许多疾病的共同特征,包括心血管疾病、肿瘤、神经退行性疾病等。干细胞外泌体中含有多种抗氧化物质,例如超氧化物歧化酶、谷胱甘肽过氧化物酶等,这些物质可以清除自由基和其他有害物质,从而减轻氧化应激的损伤。
4. 抗凋亡
细胞凋亡是许多疾病的共同特征,包括心血管疾病、肿瘤、神经退行性疾病等。干细胞外泌体中含有多种抗凋亡因子,例如Bcl-2、Bcl-xL等,这些物质可以抑制细胞凋亡的发生和发展,从而有望治疗多种凋亡性疾病。
5. 促进血管生成
血管生成是组织再生和修复的重要过程,也是多种疾病的治疗靶点。干细胞外泌体中含有多种血管生成因子,例如VEGF、FGF等,这些物质可以促进血管内皮细胞的增殖和分化,从而促进血管生成和组织修复。
总之,干细胞外泌体具有多种作用,包括促进组织修复、抗炎、抗氧化、抗凋亡、促进血管生成等。这些作用使得干细胞外泌体成为一种非常有前途的新型治疗方法,有望治疗多种疾病。但是,目前干细胞外泌体的研究还处于初级阶段,需要进一步的研究来验证其疗效和安全性。










发表评论